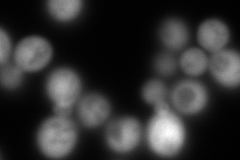
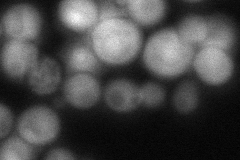

View description
Protein with sequence similarity to 2,3-diketo-5-methylthiopentyl-1-phosphate enolase-phosphatases, involved in methionine salvage; found in both the cytoplasm and nucleus
Localization:
Intensity:
Fold change:
Significance:
-
C’ GFP library in SD

below threshold17.23 -
N' NOP1pr-GFP in SD

cytosol276.592 -
N' TEF2pr-mCherry in SD
cytosol403.25 -
N' NATIVEpr-GFP in SD
cytosol84.2379 -
N' TEF2pr-VC and Cyto-VN in SD

cytosol77.5416 -
C’ GFP library in SD+DTT

cytosol17.481.01No -
C’ GFP library in SD+H2O2

cytosol14.740.85No -
C’ GFP library in Starvation Media

cytosol16.870.97No -
C’ GFP library on the background of Pup2-DaMP

below threshold -
C’ GFP library on the background of CCT mutant

below threshold16.97690.984904No
